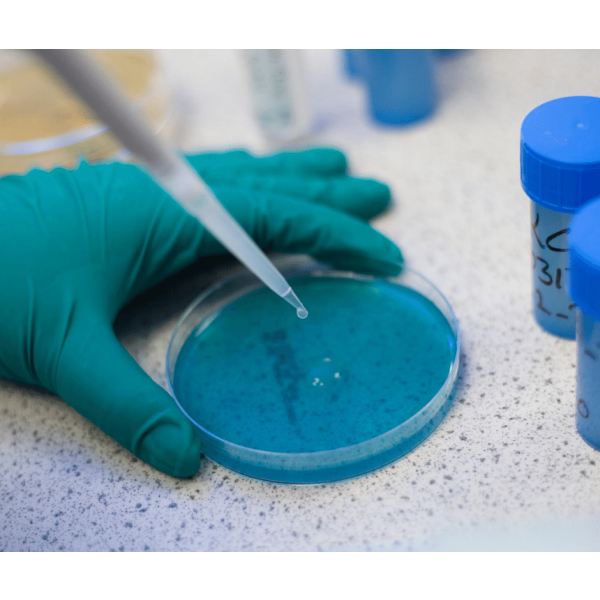
Sample Analysis By Direct Plating

Order before 2pm for UK next day shipping | US | EXPORT
Sample Analysis by Direct Plating
Detect and quantify microbial contaminants using four types of selective media (lysine, copper sulphate, WLD, anaerobic Raka-Ray).
Availability:
In stock
SKU
LAB-MICRODP
Direct plating is a common microbiological technique used in the brewing industry to detect and quantify microbial contaminants in beer and brewing environments. This method helps breweries monitor the presence of spoilage organisms such as Lactobacillus, Pediococcus, Saccharomyces wild yeasts, and other contaminants that can affect beer quality.
| Vegan | No |
|---|
Need technical advice?
Find all the your TDS and SDS here.
Talk to the people in the know by calling one of our qualified brewers and winemakers on 0115 978 5494




Murphy & Son, Alpine Street, Old Basford, Nottingham, NG6 0HQ, United Kingdom.
Murphy & Son Ltd | 0115 978 5494 | Legal Pages